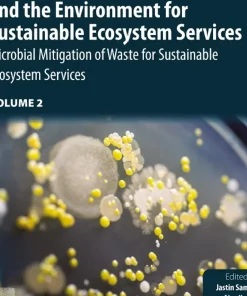
Relationship Between Microbes and the Environment for Sustainable Ecosystem Services Volume 2

Shop
Showing 5761–5769 of 26071 results
Filter by price
Product categories
- Acupuncture Book (5)
- Aids Books (6)
- Allergy Books (4)
- Alzheimer Book (38)
- AMC Books (13)
- Anatomy and Physiology (181)
- Anatomy Books (519)
- Anesthesia Books (469)
- Animal Biology Books (132)
- Asthma Books (107)
- Audiology Books (78)
- Bacteriology (95)
- Biochemistry Books (856)
- Biochemistry Physics Books (25)
- Bioelectronics Books (13)
- Bioethics Books (79)
- Bioinformatics Books (113)
- Biomechanics Books (49)
- Biometrics Books (15)
- Biophysics Books (32)
- Biopolymer Books (67)
- Biostatistics Books (61)
- Biotechnology Books (373)
- Blood Transfusion Books (36)
- Cardiology Books (1649)
- Cellular and Molecular Biology Books (204)
- Dental Books (10)
- Diabetes Books (56)
- Embryology Books (58)
- Endocrinology Books (145)
- Entomology Books (34)
- Epidemiology Books (335)
- Epilepsy Books (19)
- Family Medicine Books (8)
- FCPS Books (79)
- Fisheries and Aquaculture Books (49)
- Food Industry and Nutrition Books (352)
- Forensic Medicine Books (124)
- Gene Therapy Books (13)
- Genomics Books (23)
- Gynaecology Books (91)
- Histology Books (47)
- Human Genetics Books (182)
- Hygiene and Health Books (758)
- IBCLC Exam Books (9)
- Immunology Books (238)
- Infectious Disease Books (70)
- Internal Medicine Books (130)
- Laboratory Sciences Books (112)
- Medical Books (3098)
- Medical Documents books (9)
- Medical Education Books (544)
- Medical Informatics Books (39)
- Metabolics Books (19)
- Microbiology Books (167)
- MRCOG Books (39)
- Mrcp Books (29)
- Nephrology Books (393)
- Neurology Books (288)
- Non-Medical (8833)
- Nursing Books (1073)
- Nutrition Books (123)
- Oncology Books (269)
- Oxford Books (37)
- Paediatrics Books (69)
- Parasitology Books (17)
- Parkinson Books (4)
- Pharmacology Books (396)
- Pharmacy Books (338)
- Physiotherapy Books (13)
- Plab Books (11)
- Proteomics Books (19)
- Pulmonology Books (69)
- Regenerative Medicine Books (14)
- Rehabilitation Books (49)
- Rheumatology Books (9)
- Scrub (35)
- Sports Medicine Books (188)
- Telemedicine and Health Books (27)
- Traditional Medicine Books (78)
- Tropical Medicine Books (3)
- Urology and Nephrology Books (66)
- Uworld & Usmle Books (15)
- Veterinary and Animal Science Books (1373)
Top Rated Products
Showing 19201–19230 of 26071 results
-

Regulatory T cells and Autoimmune Diseases
د.إ1,470.00 Quick View Compare -

Regulatory Toxicology: Essentially Practical Aspects By Renuka Sengupta
د.إ15,000.00 Quick View Compare -

Rehab Science How to Overcome Pain and Heal from Injury
د.إ295.00 Quick View Compare -

Rehabilitation from COVID-19 An Integrated Traditional Chinese and Western Medicine Protocol
د.إ500.00 Quick View Compare -

Rehabilitation interventions in the patient with obesity
د.إ668.00 Quick View Compare -

Rehabilitation of Metallic Structural Systems Using Fiber Reinforced Polymer (Frp) Composites
Call for Price Quick View Compare -

Rehabilitation of Stroke
Call for Price Quick View Compare -

Rehabilitation Robotics and Healthcare Devices
د.إ940.00 Quick View Compare -

Rehabilitation Robots for Neurorehabilitation in High- Low- and Middle-Income Countries
د.إ940.00 Quick View Compare -

Rehabilitation Therapeutics of the Neurological Training
د.إ999.00 Quick View Compare -

Reichmans Emergency Medicine Procedures 3rd Ed
Call for Price Quick View Compare -

Reifying Women’s Experiences with Invisible Illness Illusions Delusions Reality
د.إ321.00 Quick View Compare -

Relational and Algebraic Methods in Computer Science
د.إ225.00 Quick View Compare -

Relationship Between Microbes and the Environment for Sustainable Ecosystem Services Volume 1
د.إ1,058.00 Quick View Compare -
Relationship Between Microbes and the Environment for Sustainable Ecosystem Services Volume 2
د.إ1,058.00 Quick View Compare -

Relationship Between Microbes and the Environment for Sustainable Ecosystem Services Volume 3
د.إ1,058.00 Quick View Compare -

Relativistic Geodesy Foundations and Applications
د.إ764.00 Quick View Compare -

Relativity and Cosmology From First Principles to Interpretations
د.إ587.00 Quick View Compare -

Relax I’m a Hygienist I’ve Seen Worse
د.إ165.00 Quick View Compare -

Relax I’m a Hygienist I’ve Seen Worse
د.إ165.00 Quick View Compare -

Relax I’m a Hygienist I’ve Seen Worse
د.إ154.00 Quick View Compare -

Reliability and Survival Analysis
د.إ705.00 Quick View Compare -

Remaking Sustainable Urbanism
د.إ936.00 Quick View Compare -

Remediation of Heavy Metals Sustainable Technologies and Recent Advances
د.إ683.00 Quick View Compare -

Remediation of Plastic and Microplastic Waste
د.إ680.00 Quick View Compare -

Remedies To Tooth Decay Remedies To Tooth Decay
د.إ135.00 Quick View Compare -

Remington and Klein’s Infectious Diseases of the Fetus and Newborn Infant
د.إ1,546.00 Quick View Compare -

Remington and Klein’s Infectious Diseases of the Fetus and Newborn Infant 8th Edition
Call for Price Quick View Compare -

Remington Education: Pharmaceutics By Shelley Chambers Fox
د.إ9,814.97 Quick View Compare -

Remington: The Science and Practice of Pharmacy 23rd Edition
د.إ40,000.00 Quick View Compare
Recently Viewed Products
No recently viewed products to display







